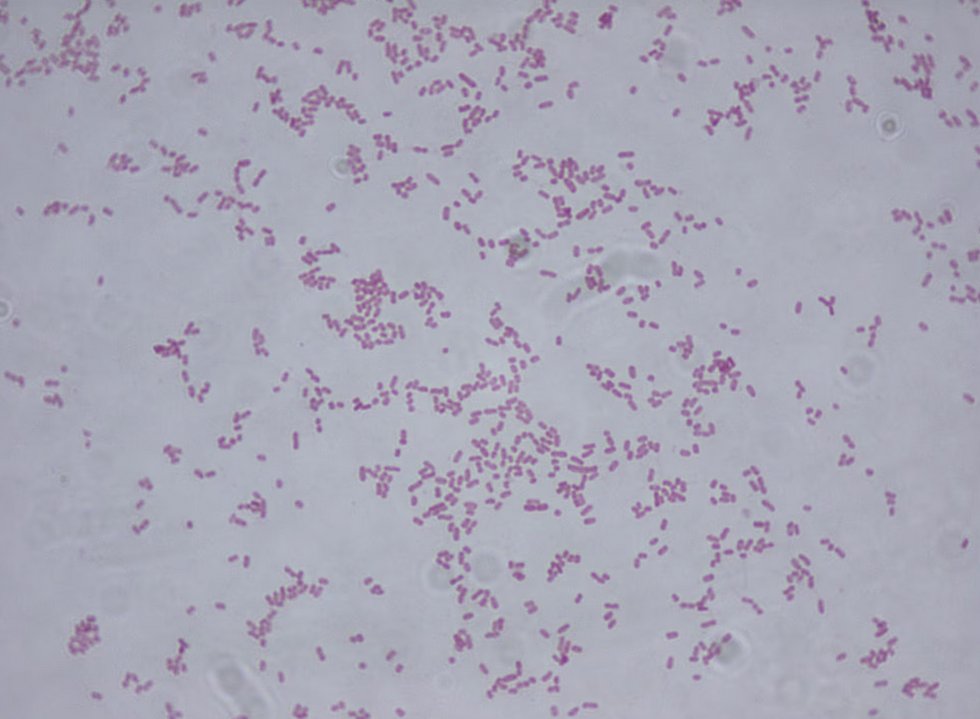
bacteria Klebsiella oxytoca

Los pacientes, de 0 a 14 años, presentaban un estado delicado de salud. Otros siete menores, la mayoría recién nacidos, siguen hospitalizados

Almudena Barragán / Darinka Rodríguez / El País
Al menos 13 niños han fallecido en hospitales del Estado de México por un posible contagio con la bacteria Klebsiella oxytoca. Las autoridades sanitarias apuntan a que el brote está relacionado con la contaminación de la solución intravenosa de nutrición parentenal total (NPT), un método de alimentación a través del torrente sanguíneo para pacientes que no pueden ingerir alimentos.
Los fallecidos tenían entre 0 y 14 años y estaban ingresados con alguna comorbilidad. Otros siete menores, la mayoría de ellos recién nacidos, permanecen hospitalizados con síntomas parecidos. En total, el número de casos positivos asciende a 20, otros cuatro se encuentran en observación y uno ya ha sido descartado.
La Secretaría de Salud investiga las causas exactas de la muerte de los menores, aunque todo apunta al contagio por la peligrosa bacteria. “De los 20 casos, se registraron 13 defunciones de pacientes que poseían comorbilidades por lo que se encuentran en proceso de dictaminación para determinar si la causa de muerte está asociada a la ITS por Klebsiella oxytoca MDR”, ha explicado la dependencia en un comunicado.
Las autoridades sanitarias emitieron este martes una alerta epidemiológica para todos los hospitales del país. Salud no descarta que el foco de la infección pueda encontrarse en los insumos relacionados con la aplicación de la NPT, por lo que extendió la advertencia a todas las unidades médicas, de vigilancia epidemiológica y de regulación y riesgos sanitarios del Sistema Nacional de Salud.
“Tras recibir la notificación oportuna de las autoridades del Estado de México ante la identificación de un posible vínculo entre los casos de los diferentes hospitales, el 29 de noviembre, las Secretaría de Salud del Gobierno de México y la estatal procedieron a instalar de inmediato el Comando de Gestión de Incidentes en Salud Pública para investigar el brote”, explicó la Secretaría.
La Comisión Federal para la Protección contra Riesgos Sanitarios (Cofepris), por su parte, emitió otra alerta para informar a los profesionales de la salud sobre la inmovilización de manera preventiva y la suspensión del uso de soluciones intravenosas de nutrición parenteral preparadas a partir del 21 de noviembre por la empresa SAFE, con razón social Productos Hospitalarios S.A. de C.V.
“Los análisis en curso buscan identificar la fuente del brote y se mantiene un monitoreo permanente para descartar posibles brotes en otras entidades”, ha detallado la Cofepris, aunque las autoridades no descartan otras hipótesis de cómo pudo suceder el contagio. Hasta el momento se desconoce el alcance de la contaminación y si podría llegar a otros Estados. El primer foco fue detectado en tres hospitales públicos y una clínica privada del Estado de México, pero podría haber más.
La Klebsiella oxytoca suele encontrarse en el tracto gastrointestinal de humanos, animales o en el medio ambiente y puede causar infecciones graves en personas con sistemas inmunes debilitados, como era el caso de los menores fallecidos. Los pacientes pediátricos y las personas con largos periodos de hospitalización son los más vulnerables a sufrir el ataque de una bacteria.
En el caso de la Klebsiella el contagio sucede de manera intravenosa y no por vía aérea o a través de la piel. De hecho, las infecciones bacterianas comunes son la segunda causa de muerte en el mundo. En 2019, unos 7,7 millones de personas murieron por este tipo de contagios, como demuestra un estudio internacional publicado por la revista The Lancet.
Las infecciones provocadas por el patógeno suelen presentar fiebre alta y escalofríos, aceleración del ritmo cardíaco (taquicardia), problemas para respirar o inflamación de todo el cuerpo como respuesta a una infección generalizada grave.
“Las infecciones por Klebsiella son un problema de salud pública importante, principalmente en el ámbito hospitalario, debido a su frecuencia, gravedad y resistencia a los antibióticos, lo que hace que el tratamiento sea más difícil”, apuntan desde la Secretaría de Salud.
La Cofepris señala que están realizando investigaciones en los centros hospitalarios detectados para encontrar las causas, dando trazabilidad y rastreo de los insumos que puedan ser la fuente de las infecciones. Por su parte, la Secretaría de Salud, en coordinación con otras autoridades sanitarias, subraya que continuarán con las investigaciones para “establecer la fuente del brote” y trabajarán de manera conjunta para “prevenir futuros eventos similares”.